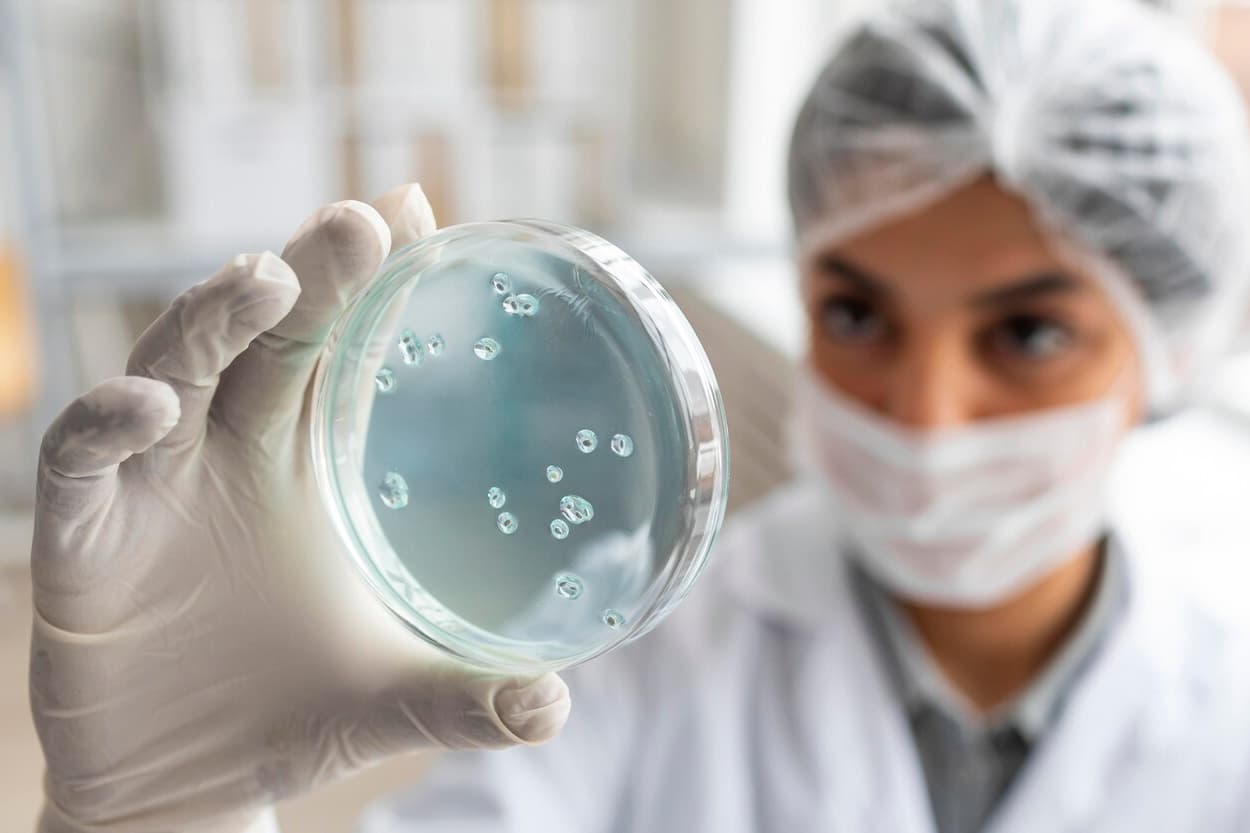
Импорт в Россию молока и мяса приостановлен из-за оспы

В Екатеринбурге остановили поезд, в котором умерла 7-месячная девочка

Вечером девятого января 2024 года произошла страшная трагедия: прямо на борту поезда, который следовал по маршруту «Москва — Чита», умер семимесячный ребенок. Предварительной причиной гибели малышки стал грипп. Об этом сообщают в КП-Екатеринбург.
Мать девочки и двое ее сыновей также заразились инфекцией и почувствовали те же симптомы, которые наблюдались у погибшей девочки: температуру в районе 38 градусов и слабость. Семью экстренно госпитализировали в Центральнуб городскую больницу Кунгура, однако грудничка спасти не удалось.
Спустя 40 минут стоянки в Кунгуре состав продолжил движение, но вновь был остановлен в Екатеринбурге. В целях предотвращения локальной эпидемии уральские медики осмотрели пассажиров поезда, провели санитарную обработку и провели тесты на COVID-19 и грипп.
Есть информация о том, что тесты на коронавирусную инфекцию были отрицательными, но среди пассажиров мог распространиться вирус «свиного гриппа» H1N1. Уральская транспортная прокуратура устроила проверку о соблюдении санитарного порядка на борту железнодорожного состава.
Автор статьи
Реакции:
Поделиться: